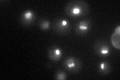
YOL010W

View description
Subunit of U3-containing 90S preribosome processome complex involved in 18S rRNA biogenesis and small ribosomal subunit assembly; stimulates Bms1p GTPase and U3 binding activity; similar to RNA cyclase-like proteins but no activity detected
Localization:
Intensity:
Fold change:
Significance:
-
C’ GFP library in SD

nucleus84.01 -
N' NOP1pr-GFP in SD

nucleus,nucleolus80.5495 -
N' TEF2pr-mCherry in SD

nucleus,nucleolus49.4967 -
N' NATIVEpr-GFP in SD

nucleolus59.6527 -
N' TEF2pr-VC and Cyto-VN in SD

nucleus,nucleolus45.1343 -
C’ GFP library in SD+DTT

nucleus65.570.78No -
C’ GFP library in SD+H2O2

nucleus82.610.98No -
C’ GFP library in Starvation Media
nucleus71.070.84No -
C’ GFP library on the background of Pup2-DaMP

nucleus -
C’ GFP library on the background of CCT mutant

nucleus87.15491.03734No
